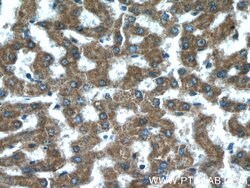
FZR1 Rabbit anti-Human, Mouse, Rat, Polyclonal, Proteintech 20 &mu;L; Unconjugated:Antikörper

missing translation for 'onlineSavingsMsg'
Learn More
Learn More
Beschreibung
FZR is a 7WD domain family member implicated in cell cycle regulation of Drosophila and yeast. It has been shown that the over expression of fzr proteins increases natural killer cell-mediated cell death and as a result, suppresses tumor growth. The fzr protein is essential for cyclosome activity.
Spezifikation
Spezifikation
| Antigen | FZR1 |
| Anwendungen | Immunohistochemistry (Paraffin), Immunocytochemistry, Immunofluorescence, Immunoprecipitation, Western Blot |
| Klassifikation | Polyclonal |
| Konzentration | 0.22 mg/mL |
| Konjugat | Unconjugated |
| Zusammensetzung | PBS with 50% glycerol and 0.02% sodium azide; pH 7.3 |
| Gen | FZR1 |
| Gen-Zugriffsnummer | Q9R1K5, Q9UM11 |
| Gen-Alias | CDC20 like protein 1, CDC20C, CDH1, Cdh1/Hct1 homolog, Fizzy related protein homolog, FYR, FZR, FZR1, FZR2, HCDH, HCDH1, KIAA1242 |
| Gensymbole | Fzr1 |
| Mehr anzeigen |
Name des Produkts
Indem Sie auf Absenden klicken, erklären Sie sich damit einverstanden, dass Fisher Scientific sich mit Ihnen in Verbindung setzen kann, um Ihr Feedback in diesem Formular zu bearbeiten. Wir werden Ihre Informationen nicht für andere Zwecke weitergeben. Alle bereitgestellten Kontaktinformationen werden in Übereinstimmung mit unserer Datenschutzrichtlinie aufbewahrt. Datenschutzrichtlinie.
Haben Sie Verbesserungsvorschläge?